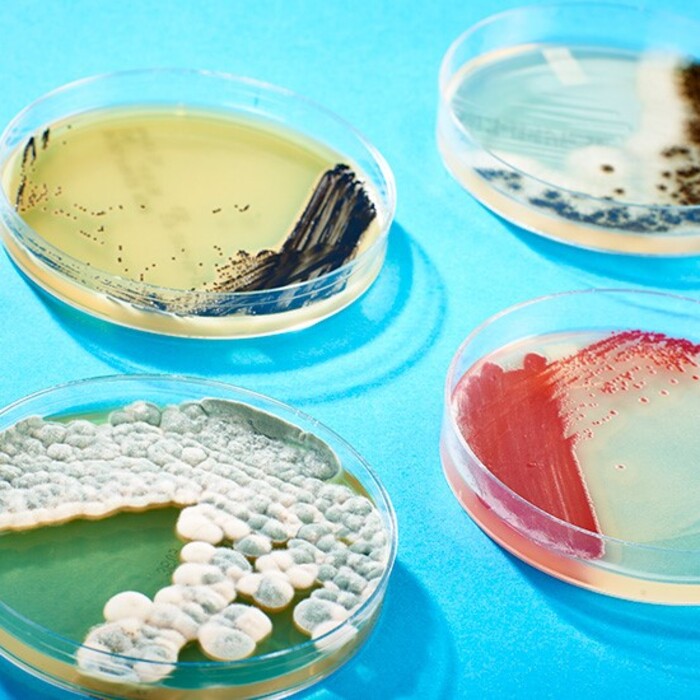
petrita_700x700_crop_478b24840a

17 септември - Световен ден на микроорганизмите
Отворени врати на 19.09 2022 г. в УПИЗ „Учебно-научна лаборатория по Биология”-МФ
Корпус 1, Ниво -1, Помещение 04
Организатори:
департамент „Природни науки”
УПИЗ „Учебно-научна лаборатория по Биология”-МФ
На 17 септември цялото човечество отбеляза Световния ден на микроорганизмите. Тази дата е избрана в памет на откривателя на микроорганизмите - Антъни ван Льовенхук.
На 17 септември 1683 г. холандският търговец на платове и общински служител, без университетско образование, Антъни ван Льовенхук изпраща своето писмо до Лондонското кралско дружество, в което за първи път описва „малките животинки” - бактериите. По онова време той не знае нищо за тяхното клетъчно устройство и морфология, но успява приблизително да ги преброи в проба от зъбен налеп от собствената си устна кухина: „ужасно много са, те са повече от хората в Холандия” и да охарактеризира тяхното движение - „блъскат се като луди”. Льовенхук открива тези миниатюрни живи организми и в прозрачната дъждовна вода и във фецес. Той е откривателят и на сперматозоидите и еритроцитите, които изследва също от лични проби и с помощта на конструираните от него многобройни, примитивно изглеждащи, но с много прецизни лещи микроскопи. Най-близкият музей, където може да бъде видян един от неговите микроскопи е Природонаучния музей във Виена. През следващата 2023 година се навършват 300 години от неговата смърт и тя ще бъде обявена за „Година на Льовенхук”. Значима годишнина микробиолозите отбелязват и през настоящата 2022 г. – 200 години от рождението на великия Луи Пастьор. Химик по образование, той прави фундаментални открития в областта на медицината и биологията, с което си спечелва омразата на обществото не само на френските, но и и на европейските лекари. Неговите фундаментални открития са свързани с въвеждането на термина „ваксина”, създаването на ваксина срещу бяса и антракса, изясняване механизма на ферментациите, изобретяване на метода „пастьоризация”, оборване на теорията за самозараждането на живота, конструирайки колбата с лебедова шия. Пастьор помага интензивно и на индустрията изследвайки и установявайки причините за вкисване на виното на френските винари и изясняването на причините за заболяване по копринените буби, спасявайки тези две индустрии от разруха. Негови са крилатите фрази „Съдбата помага на подготвения ум”, „Малко наука ни държи далеч от Бога, а много наука ни доближава до него” и „Ролята на безкрайно малките е безкрайно голяма”. Нов български университет също ще отбележи Световния ден на микроорганизмите с Отворени врати в УПИЗ „Учебно-научна лаборатория по Биология” на 19.09. 2022 (понеделник), от 15 ч. с демонстрация на различни видове микроорганизми.
Източник снимка: https://blog.microbiologics.com/tag/growth-requirements/